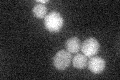

View description
DNA-binding protein involved in either activation or repression of transcription, depending on binding site context; also binds telomere sequences and plays a role in telomeric position effect (silencing) and telomere structure
Localization:
Intensity:
Fold change:
Significance:
-
C’ GFP library in SD
cytosol22.35 -
N' NOP1pr-GFP in SD

nucleus126.492 -
N' TEF2pr-mCherry in SD

missing0 -
N' NATIVEpr-GFP in SD

punctate,nucleus34.5942 -
N' TEF2pr-VC and Cyto-VN in SD

nucleus60.7916 -
C’ GFP library in SD+DTT

cytosol30.621.36Yes -
C’ GFP library in SD+H2O2

cytosol22.260.99No -
C’ GFP library in Starvation Media

cytosol21.940.98No -
C’ GFP library on the background of Pup2-DaMP

cytosol -
C’ GFP library on the background of CCT mutant

cytosol34.44341.54016Yes
